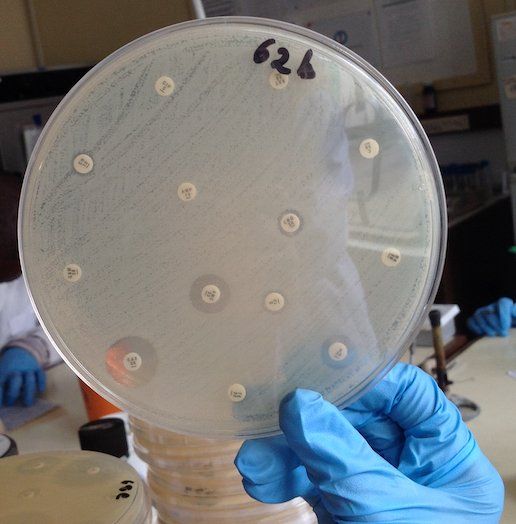

zoonoticdisease
@zoonoticdisease.bsky.social
130 followers
40 following
20 posts
News from a research team @LivUni_IVES @ILRI studying #zoonoticdiseases & emerging diseases #EIDs in East Africa. By @ericfevre & team. Recently moved here from former Twitter....
Posts
Media
Videos
Starter Packs
Reposted by zoonoticdisease
Reposted by zoonoticdisease